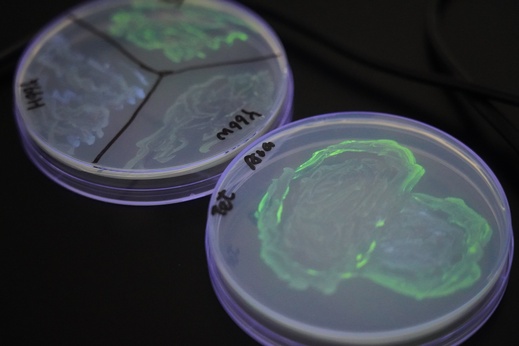
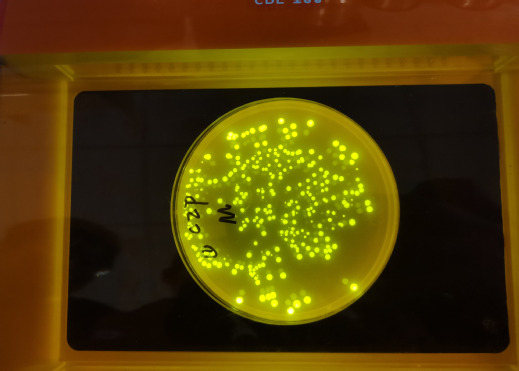

4月25日,我校高中部生物与物理导师小组走进中国科学技术大学生命科学与医学部公共实验室,开展跨学科联合研学活动。石彩玲、张巨扬、王玲、代亚运四位导师带领23名学生参与本次活动,在理论学习、实验实操与科研探访中,感受生命科学与物理学科交叉融合的独特魅力。
中科大生医部教授张璇首先围绕PCR技术与分子电泳实验核心原理展开专题授课,结合基因检测、疾病诊断等前沿应用案例,将 DNA 变性、退火、延伸的循环机制及琼脂糖凝胶电泳分离原理,转化为通俗易懂的知识要点,为同学们搭建起理论与实践的认知桥梁。同时同步衔接电磁、光学等基础原理,引导学生从跨学科视角理解实验设备运行逻辑与技术应用场景,实现生物知识与物理思维的有机融合。
在高校导师与研究生助教的悉心指导下,同学们分组进入公共实验室开展实操训练。大家规范完成PCR样品添加、固体培养基配制及灭菌、LB平板配制、质粒转化、涂布平板等关键步骤。实操过程中,生物导师细致把控实验规范,物理导师实时解析仪器原理,双学科导师协同护航,让同学们在动手实践中锤炼严谨科研素养,真切体会科学实验的严谨性与趣味性。
![]() | ![]() | |
![]() | ![]() | |
![]() | ![]() |
随后,同学们依次体验PCR程序设定操作,近距离观察转基因绿色、蓝色荧光大肠杆菌平板荧光激发现象,亲手开展转基因荧光大肠杆菌创意作画实践。一系列趣味化、探究式实验体验,将微观生命现象与前沿生物技术相结合,直观展现转基因技术的神奇与魅力,让同学们切实感受到生命科学的趣味性与探索价值。
![]() | ![]() | |
![]() | ![]() |
此次联合研学活动是我校导师制育人模式的创新实践。活动不仅让同学们直观掌握分子生物学实验技能,更在跨学科探究中激发科学探究兴趣,坚定投身科研、科技报国的理想信念。我校将持续深化导师制育人体系,丰富研学形式与内容,为创新人才早期培养搭建更广阔的平台。
供稿:德育处 高一年级组 张巨扬
一审:赵子君
二审:蒋克兢
三审:黄乃斌